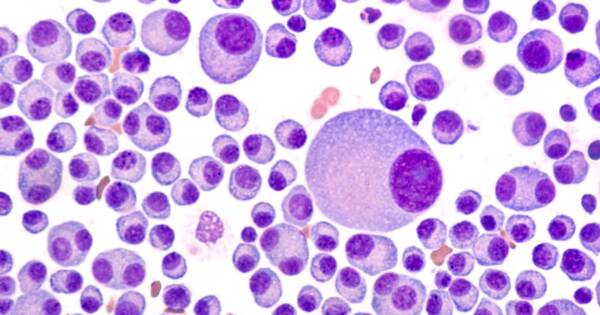

Health
Health
Know Your Rights: How to Get Compensation for Asbestos Exposure
Asbestos, a material once widely used in various industries, has been linked to severe health conditions. For decades, many individuals unknowingly faced exposure risks in their workplaces or homes. If you or someone you know has been exposed to asbestos, you might be entitled to compensation. Today, we’ll explore the topic in depth to help […]
4 minute read